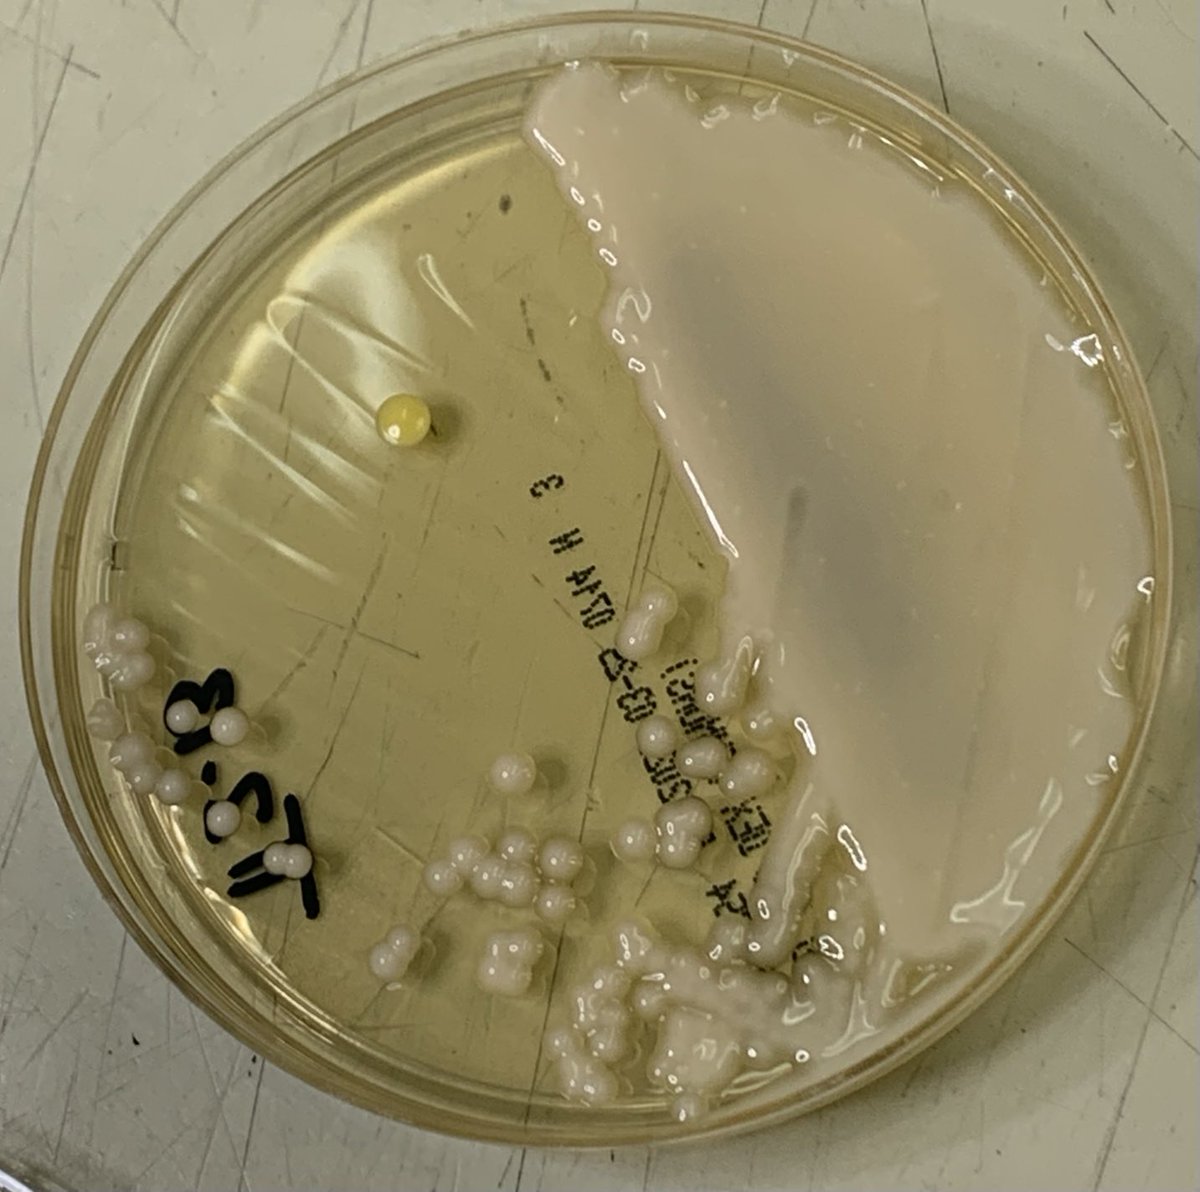
ECUHealth_ID's tweet image. Micro/Path rounds #cryptococcus   BAL… nice capsule 🔬 creamy, mucoid colonies 🧫 #IDFellowship #microbiology #IDTwitter
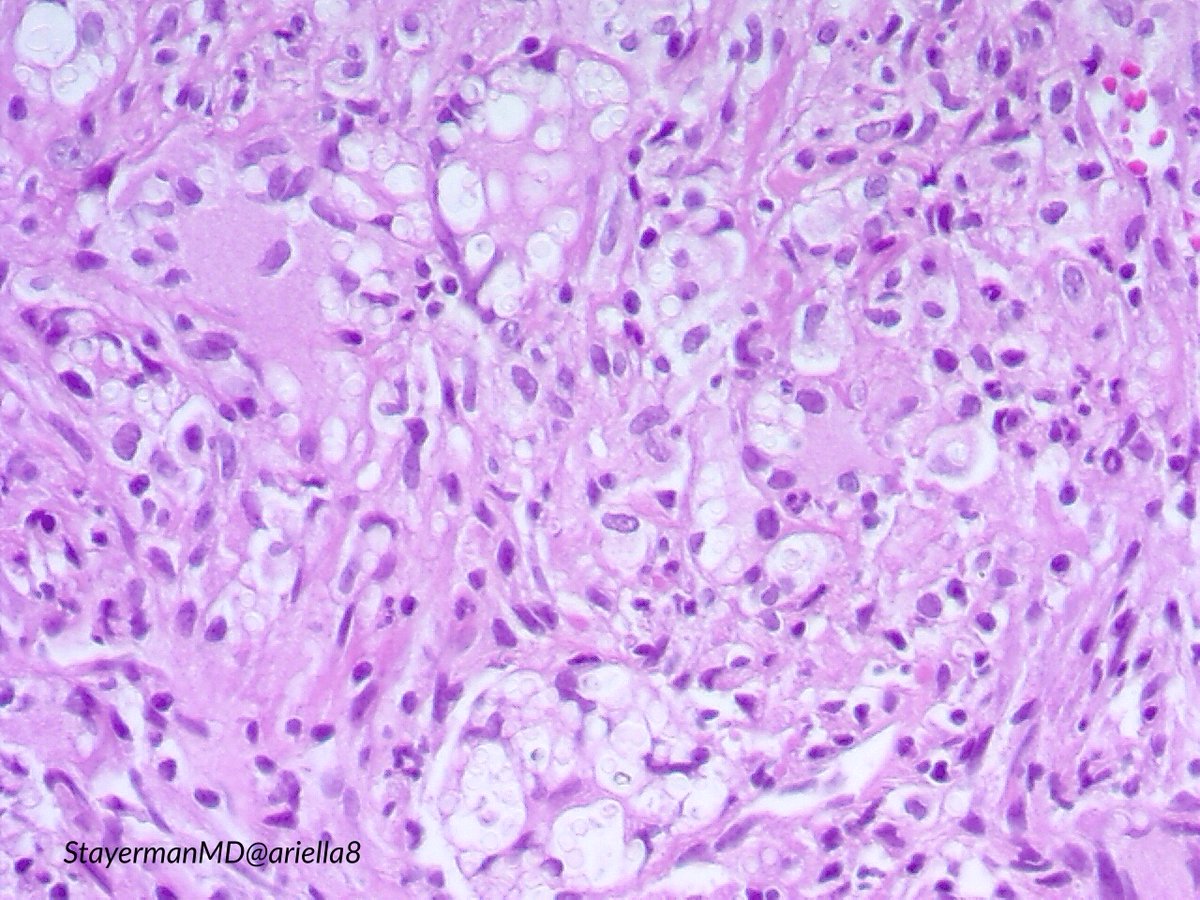
ariella8's tweet image. #Pulmpath #Thoracicpath #Pathbugs 1/2
Excited again to share a case that crossed my microscope 
Peripheral pleural based masses, sent with DX Ca versus round pneumonia (up to 5 cm ).
It is part of  #Pathtweeter history 
Look at the first set ,make your DX , then go to 2nd 👉
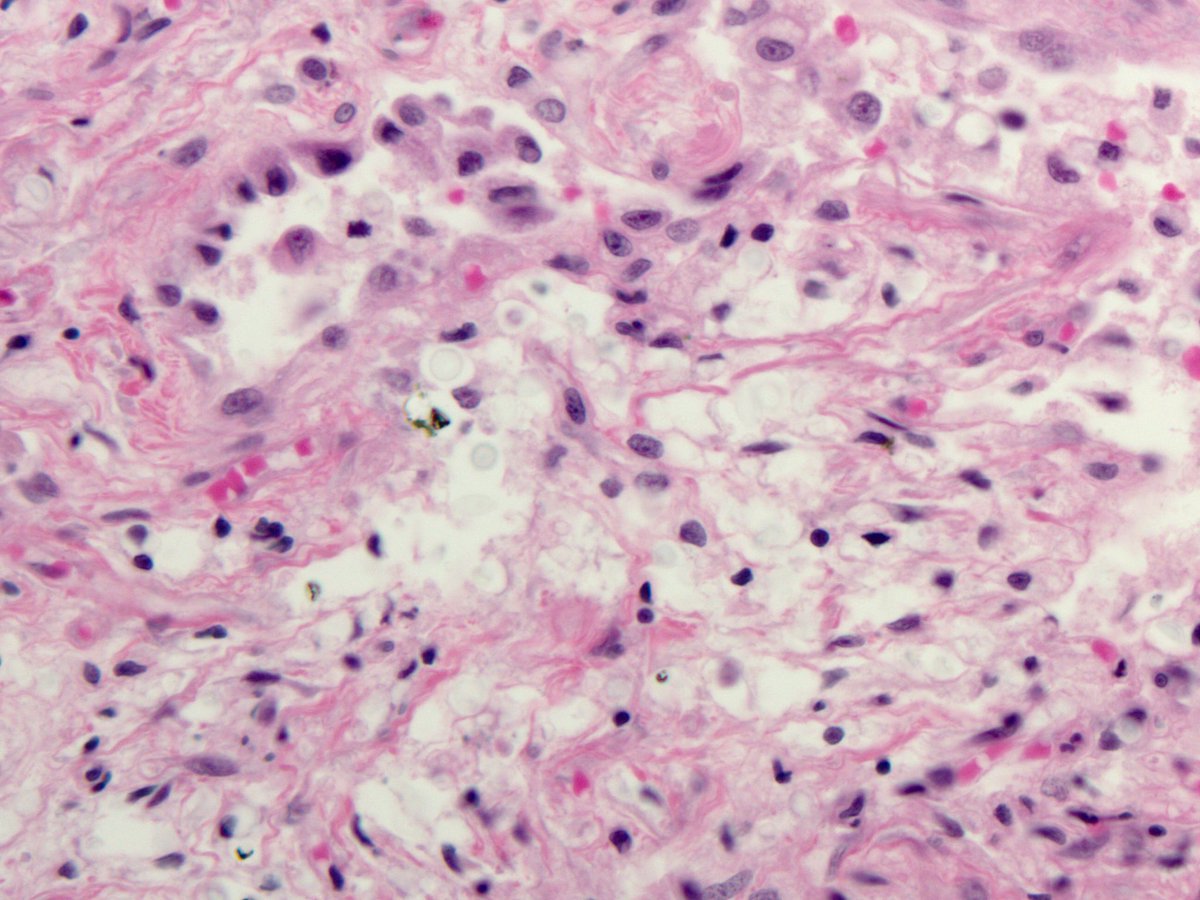
smlungpathguy's tweet image. See the halo around these #Cryptococcus yeasts? Textbooks say it’s the capsule. If this were true, the halo would stain with mucicarmine. It doesn’t! 😬😳🧐

The halo is an artefact caused by retraction of the cytoplasm of the cell engulfing the yeasts 

#pathology #pulmpath
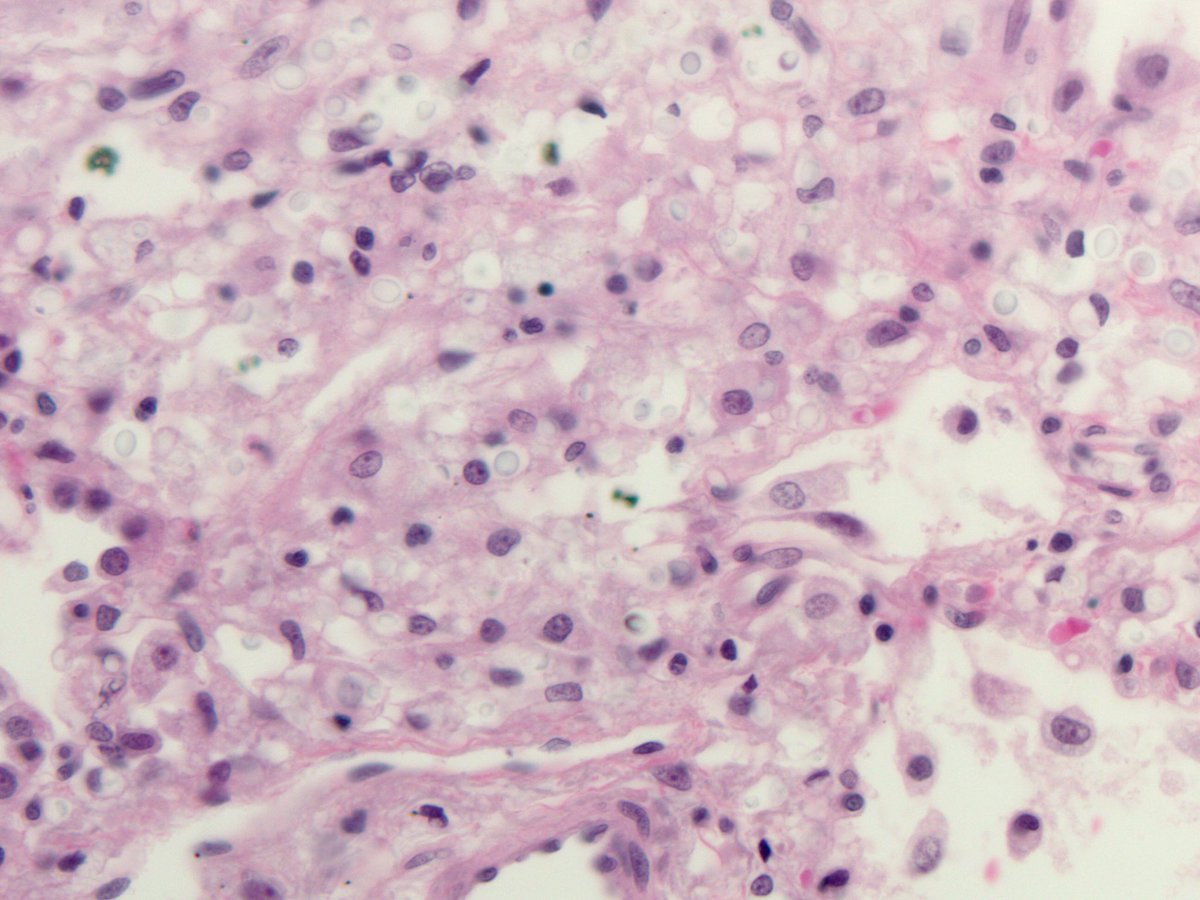
smlungpathguy's tweet image. See the halo around these #Cryptococcus yeasts? Textbooks say it’s the capsule. If this were true, the halo would stain with mucicarmine. It doesn’t! 😬😳🧐

The halo is an artefact caused by retraction of the cytoplasm of the cell engulfing the yeasts 

#pathology #pulmpath
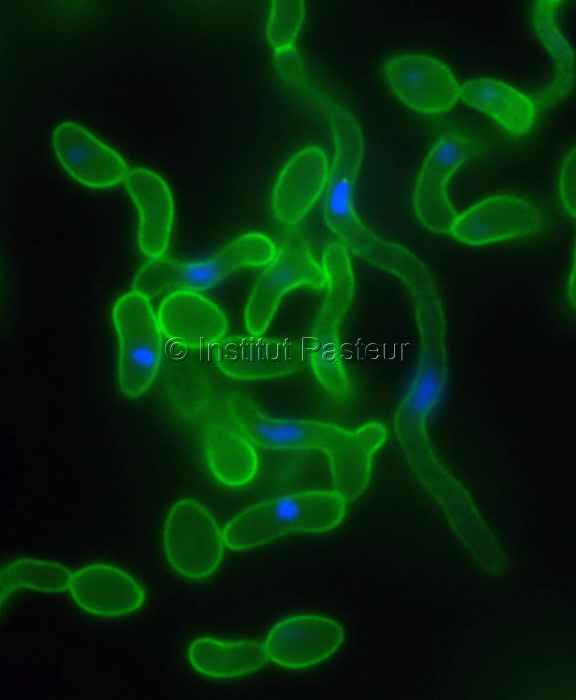
MicrobesInfect's tweet image. Studying fungal pathogens of humans and fungal infections:

Fungal diversity and diversity of approaches

sciencedirect.com/science/articl… #Cryptococcus #Aspergillus #Candida
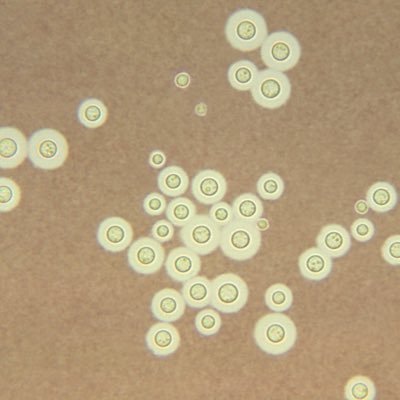
wows2005's profile picture.

#cryptococcus 搜尋結果
🚨🚨Cambio nombre d algunas LEVADURAS🚨🚨Afecta a #Candida (principales 📸1) #Cryptococcus (no neoformans) #Pseudozyma, #Geotrichum, #Pichia y #Trichosporon. Algunos fáciles de reconocer: C. glabrata ➡️ Nakaseomyces glabrata 😊pero otros… C. krusei ➡️ Pichia kudriavzevii 😳🤯




🖥️ #Sesión: Hoy comentamos un caso de #criptococosis 🥜 en paciente sin factores de riesgo e inmunocompetente y hacemos una revisión de la literatura de la infección por #Cryptococcus 🍄 ¡Gracias por la sesión y enhorabuena como siempre @Pili_Viz 🫶🏻!




My picc line is in for 2 months. Today is my first day of IV antibiotics. We gonna go aggressive on this infection so I can be ready for the next health hurdle we are still trying to figure out. @MayoClinic #chronicillness #cryptococcus #pneumonia #lymphoma #fnd #mayo

#Pathbugs Yet another stellar contribution to the #Pathbugs kingdom by our guru and unmatched guide to deep #Cryptococcus knowledge @smlungpathguy . ↘️
218/ Image from case 5, table 1, Toro P, et al, Int J Surg Pathol 2025 journals.sagepub.com/doi/10.1177/10… Mucicarmine is positive in pleomorphic yeasts with a halo. Hedge or diagnose as Cryptococcus? #pathbugs #crittersontwitter

In this new #mGem review, @Sam7Rockstar and Peter R. Williamson explore the immunological mechanisms by which GM-CSF autoantibodies increase susceptibility to infections and discuss their significance as an inborn error of immunity. doi.org/10.1128/mbio.0… #mBio #Cryptococcus

🍄 Did you know? Cryptococcus, a spherical yeast-like fungus found in soil, especially where birds frequent, can impact your health! 🕊️ Curious to learn more about fungi and their fascinating world? Dive deeper at library.bustmold.com/cryptococcus/! 📚✨ #moldfacts #cryptococcus
Fungicide-tolerant persister formation during cryptococcal pulmonary infection cell.com/cell-host-micr… #Cryptococcus

Incredible week at the #ICCC in Kampala. Glastonbury for #cryptococcus! Great to connect with amazing colleagues, make new friends and discuss future collaborations. Phenomenal organisation by the team!




🔬Live from the clinical lab: direct examination after grocott methenamine silver staining of a skin biopsy in a patient with disseminated cryptococcosis. Cryptococcus neoformans yeast cells surrounded by a large capsule. 👀 #cryptococcus #thinkfungus

เชื้อคริปโตคอกโคสิส จากนกพิราบอันตรายถึงขั้นเยื่อหุ้มสมองอักเสบ #คริปโตคอกโคสิส #Cryptococcus #นกพิราบ #TNNHealth tnnthailand.com/health/217854/

Cryptococcus neoformans. Young male, hiv+. First pic - crypto antigen on serum. Titer performed & is >=1:2560. 2nd pic is csf gst on low. 3rd pic gst on high. 4th is India ink. #bacteriology #microbiology #cryptococcus




#ईगल_मैन🦅 मैंने सदैव निस्वार्थ भाव से पक्षियों कि सेवा की। मैंने कभी यह नहीं सोचा था कि यही पक्षी मेरे भाई की मृत्यु का कारण बन जाएंगे। यह मेरे जीवन का सबसे बुरा अनुभव था। #Cryptococcus 🦠 #Brain_dead

Micro/Path rounds #cryptococcus BAL… nice capsule 🔬 creamy, mucoid colonies 🧫 #IDFellowship #microbiology #IDTwitter

In a recent @CIDJournal study, Julien Coussement, MD, and colleagues conducted a multicenter retrospective study to compare the frequency of #Cryptococcus infection between patients with and without HIV and described its characteristics in patients without #HIV. The study…

The interplay between virulence mechanisms is a game changer for fungal pathogenesis #Cryptococcus The story #BehindThePaper by Rosanna Baker & @ACasadevall1 : "This project, as many discoveries in science, began with a serendipitous observation..." go.nature.com/3YIi8Ax

Fungicide-tolerant persisters: #Cryptococcus neoformans forms fungicide-tolerant persisters during lung infection. Antioxidant ergothioneine plays key roles in persistence & antidepressant sertraline shows activity against cryptococcal persisters cell.com/cell-host-micr…

There are more cases of #Cryptococcus in those without HIV than PLWH! From @FannyLanternier in @OFIDJournal, pts w/o HIV: 🚨Incidence increasing 🚨Less likely to have +CrAg 🚨Higher odds of mortality Added by @NeerajaSwamina2 to Cryptococcus 📁 transplantid.net/WCQ4E9BN

Our new #Cryptococcus team and lab, raring to go! Super excited to start this new anti-fungal drug discovery project in @DDU_Dundee and @WCAIRDundee. Many thanks to the Tres Cantos Open Lab Foundation for supporting this project. @UoDLifeSciences @dundeeuni #Fungi #drugdiscovery

#Pathbugs Yet another stellar contribution to the #Pathbugs kingdom by our guru and unmatched guide to deep #Cryptococcus knowledge @smlungpathguy . ↘️
218/ Image from case 5, table 1, Toro P, et al, Int J Surg Pathol 2025 journals.sagepub.com/doi/10.1177/10… Mucicarmine is positive in pleomorphic yeasts with a halo. Hedge or diagnose as Cryptococcus? #pathbugs #crittersontwitter

เชื้อคริปโตคอกโคสิส จากนกพิราบอันตรายถึงขั้นเยื่อหุ้มสมองอักเสบ #คริปโตคอกโคสิส #Cryptococcus #นกพิราบ #TNNHealth tnnthailand.com/health/217854/

In this new #mGem review, @Sam7Rockstar and Peter R. Williamson explore the immunological mechanisms by which GM-CSF autoantibodies increase susceptibility to infections and discuss their significance as an inborn error of immunity. doi.org/10.1128/mbio.0… #mBio #Cryptococcus

A woman presented with stroke symptoms. MRI showed brain infarcts, but arteries were clear. Multiple strokes occurred over 3 days with no heart issues. A brain biopsy revealed Cryptococcus, a fungal infection mimicking vasculitis. #cryptococcus #strokes
My picc line is in for 2 months. Today is my first day of IV antibiotics. We gonna go aggressive on this infection so I can be ready for the next health hurdle we are still trying to figure out. @MayoClinic #chronicillness #cryptococcus #pneumonia #lymphoma #fnd #mayo

🧬 New in Journal of Fungi Findings reveal Cdh1’s role in capsule formation, host interactions & immune responses - shedding light on fungal pathogenicity & potential therapeutic targets. 🔗 doi.org/10.3390/jof101… #Mycology #Pathogenesis #Cryptococcus #FungalVirulence
Excited to share the new preprint from the lab on how central carbon metabolism orchestrates Titan cell formation in #Cryptococcus #neoformans 🍄 Kudos @Phatak6Phatak for driving this project with gr8 support from all co-authors @ccmb_csir biorxiv.org/content/10.110…
#Pathbugs #infectiousdiseases "Our guru @smlungpathguy continues to shatter records with the largest and most impressive #Cryptococcus case collection out there – a true goldmine for pathologists!
213/ Cryptococcus in ascites fluid! #Pathbugs #crittersontwitter #tweetcyclopedia
🧫🔬 A new fusion reporter system for Cryptococcus neoformans offers a powerful tool to study gene expression and function in this WHO-priority fungal pathogen. 🔗 doi.org/10.3390/jof100… #FungalGenetics #Cryptococcus #ReporterGenes #MolecularBiology #JoF #SyntheticBiology
🧬Pladienolide B (human splicing inhibitor) blocks deadly #Cryptococcus neoformans fungal pathogen. When combined with FK506, it disrupts RNA splicing, preventing growth & spore germination. journals.asm.org/doi/10.1128/ms… #Antifungal #Research #fungi #fungal

#Pathbugs #Cryptococcus @smlungpathguy reminded me ,so retweeting 😄
#Pulmpath #Thoracicpath #Pathbugs 1/2 Excited again to share a case that crossed my microscope Peripheral pleural based masses, sent with DX Ca versus round pneumonia (up to 5 cm ). It is part of #Pathtweeter history Look at the first set ,make your DX , then go to 2nd 👉

#Pathbugs The incredible largest collection of #Cryptococcus by my guru @smlungpathguy ↘️
212/ Classic case. The empty spaces are a clue to the diagnosis. This diagnosis can 100% be made by pathology alone #pathology #pulmpath #pathx #pathbugs #crittersontwitter #PathTweetAward #idtwitter #tweetcyclopedia
🧫 An #IOCBPrague @CzechAcademy team led by @konvalinka_jan has developed a compound that destroys the yeast #Cryptococcus neoformans – a fungus which is life-threatening for people with weakened immune systems – in laboratory settings. 🧵 #cryptococcus #fungi #iocb…

Tým vedený prof. @konvalinka_jan připravil látku, která v laboratorních podmínkách ničí kvasinkovou houbu #Cryptococcus neoformans (kryptokokus), smrtelně nebezpečnou pro lidi s oslabeným imunitním systémem. 🧵 #chemistry #Cryptococcus #chemie #uochb #iocb #iocbprague…

🖥️ #Sesión: Hoy comentamos un caso de #criptococosis 🥜 en paciente sin factores de riesgo e inmunocompetente y hacemos una revisión de la literatura de la infección por #Cryptococcus 🍄 ¡Gracias por la sesión y enhorabuena como siempre @Pili_Viz 🫶🏻!




Cutaneous cryptococcosis: clinicians should rule out immunosuppression! #cryptococcus #tropicalmedicine #infectiousdisease #infectiouspathology #dermpath #dermatopathology #pathology #patologia #patología #dermathology




🚨🚨Cambio nombre d algunas LEVADURAS🚨🚨Afecta a #Candida (principales 📸1) #Cryptococcus (no neoformans) #Pseudozyma, #Geotrichum, #Pichia y #Trichosporon. Algunos fáciles de reconocer: C. glabrata ➡️ Nakaseomyces glabrata 😊pero otros… C. krusei ➡️ Pichia kudriavzevii 😳🤯




🖥️ #Sesión: Hoy comentamos un caso de #criptococosis 🥜 en paciente sin factores de riesgo e inmunocompetente y hacemos una revisión de la literatura de la infección por #Cryptococcus 🍄 ¡Gracias por la sesión y enhorabuena como siempre @Pili_Viz 🫶🏻!




In an HIV aids patient with chronic #Cryptococcus infection, brain biopsy shows non-necrotizing granulomas in the cortex and leptomeninges, as well as scattered organisms positive for PAS and mucicarmine. #neuropath




See the halo around these #Cryptococcus yeasts? Textbooks say it’s the capsule. If this were true, the halo would stain with mucicarmine. It doesn’t! 😬😳🧐 The halo is an artefact caused by retraction of the cytoplasm of the cell engulfing the yeasts #pathology #pulmpath

#VIH #AIDS #Cryptococcus #LFA #Cryptococcalantigen #Cryptococcalmeningitis #pulmonarycryptococcosis revista.infectologia.info/index.php/revi…

In this new #mGem review, @Sam7Rockstar and Peter R. Williamson explore the immunological mechanisms by which GM-CSF autoantibodies increase susceptibility to infections and discuss their significance as an inborn error of immunity. doi.org/10.1128/mbio.0… #mBio #Cryptococcus

There are more cases of #Cryptococcus in those without HIV than PLWH! From @FannyLanternier in @OFIDJournal, pts w/o HIV: 🚨Incidence increasing 🚨Less likely to have +CrAg 🚨Higher odds of mortality Added by @NeerajaSwamina2 to Cryptococcus 📁 transplantid.net/WCQ4E9BN

Fungal extracellular vesicles: modulating host-pathogen interactions by both the fungus and the host sciencedirect.com/science/articl… #Cryptococcus #Histoplasma #Paracoccidioides #Candida

Studying fungal pathogens of humans and fungal infections: Fungal diversity and diversity of approaches sciencedirect.com/science/articl… #Cryptococcus #Aspergillus #Candida
An article entitled “Lack of Association between Fluconazole Susceptibility and ERG11 Nucleotide Polymorphisms in #Cryptococcus neoformans Clinical Isolates from Uganda” from David B. Meya et al. View full text at mdpi.com/2309-608X/8/5/…


Day 2 of @FEBSnews In vivo alternative #infection models: excellent overview by @RhysFarrer1 of #cryptococcus lineages and genomes. @LeibnizHKI

Our IM senior resident @ZYetmar and ID fellow @ecanocevallos and faculty @RazonableMD presents their study on #Cryptococcus other than neoformans and gatti These species rarely cause invasive disease!!! @RazonableMD @MayoMN_IMRES @ecanocevallos

A review entitled “Cell Wall Integrity Pathway Involved in Morphogenesis, Virulence and #Antifungal Susceptibility in #Cryptococcus neoformans” from Haroldo Cesar de Oliveira et al. View full text at mdpi.com/2309-608X/7/10…

Something went wrong.
Something went wrong.
United States Trends
- 1. Syracuse 5,465 posts
- 2. #UFCQatar 67.4K posts
- 3. Harden 25.4K posts
- 4. Arman 20.3K posts
- 5. Belal 9,802 posts
- 6. Ian Garry 8,044 posts
- 7. Fran Brown N/A
- 8. Mercer 2,804 posts
- 9. Mizzou 5,957 posts
- 10. Makai Lemon 1,015 posts
- 11. Dan Hooker 5,942 posts
- 12. #GoIrish 3,690 posts
- 13. Malik Benson N/A
- 14. Mike Washington N/A
- 15. Deuce Knight 1,761 posts
- 16. Stoops N/A
- 17. Andrew Marsh N/A
- 18. Oklahoma 23K posts
- 19. Arbuckle 1,829 posts
- 20. Maiava N/A